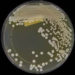
ABD'de ilaca dayanıklı mantar hastalığı yayılıyor

Çevre, Şehircilik ve İklim Değişikliği Bakanlığı Yapı İşleri Genel Müdürü Banu Aslan, Kahramanmaraş merkezli depremlerde yapı denetimli olup orta ve üzeri yapısal hasar alan bina sayısının 216 olduğunu söyledi.
Kahramanmaraş merkezli deprem felaketinin tüm boyutlarıyla araştırılması için kurulan Deprem Araştırma Komisyonu, AK Parti Afyonkarahisar Milletvekili Veysel Eroğlu başkanlığında toplandı. Çevre, Şehircilik ve İklim Değişikliği Bakanlığı Yapı İşleri Genel Müdürü Banu Aslan, komisyon üyelerine sunum yaptı. Aslan, depremlerden etkilenen 11 ilin yanı sıra gelen talepler doğrultusunda 9 ilde daha hasar tespit çalışmaları yapıldığını belirterek, “Şu ana kadar hasar tespit çalışmaları biten 6 il var. Diğer illerin tamamlanma ortalamaları da yüzde 96. Şanlıurfa ve Adana’yı 4-5 gün içinde tamamen bitirmeyi hedefliyoruz” dedi.
Natamam yapıların incelemesini yaptıklarını belirten Aslan, “11 ilde, 27 bin natamam yapı var. Bunların 16 bininin incelemesi, öğretim elemanları tarafından tamamlandı. Bunlardan yaklaşık 98 tanesinin hiçbir şekilde inşaatına devam edilemeyeceği belirtildi ve yıkım kararı alındı. ‘1132 civarı yapının, kesinlikle güçlendirilmesi gerekiyor’ denildi” ifadelerini kullandı.
Aslan, 130 binin üzerinde bina için Bina Kimlik Sertifikası alındığını ve sertifikası olan tüm yapılara 5 yılda bir denetim zorunluluğu getirildiğini söyledi.
CHP Adana Milletvekili Müzeyyen Şevkin’in depremlerde yapı denetimli kaç binanın yıkıldığı sorusuna Aslan, “Yapı denetimli olup orta ve üzeri yapısal hasar alan yapı sayısı 216” dedi.
CHP İstanbul Milletvekili Gökan Zeybek, İstanbul özelinde ve Türkiye genelindeki afet hazırlıkları ile ilgili düzenleme önerilerini komisyonda açıkladı. Zeybek, düzenlemenin ‘imar affı’nın Anayasa ile yasaklanması, İstanbul’da imar revizyonu ve ‘İmar Yasası’nda değişiklikler öngördüğünü anlattı.
CHP Hatay Milletvekili Suzan Şahin, deprem bölgelerinde gelir kaybına uğrayan belediyelerin bütçelerinin revize edilmesi gerektiğini söyledi.
Komisyon Başkan Vekili AK Parti Sakarya Milletvekili Recep Uncuoğlu da yapı denetimi uygulamasına ilişkin, “Depremden etkilenen 11 ilde, 2011 yılından bu yana 151 bin 909 bina yapı denetiminden yararlanmış. Bizdeki verilere göre, bu bölgede yıkılan bina sayısı 132. Yapı denetiminin yüzde 99 oranında başarılı olduğunu bu depremde de görmüş olduk” diye konuştu.